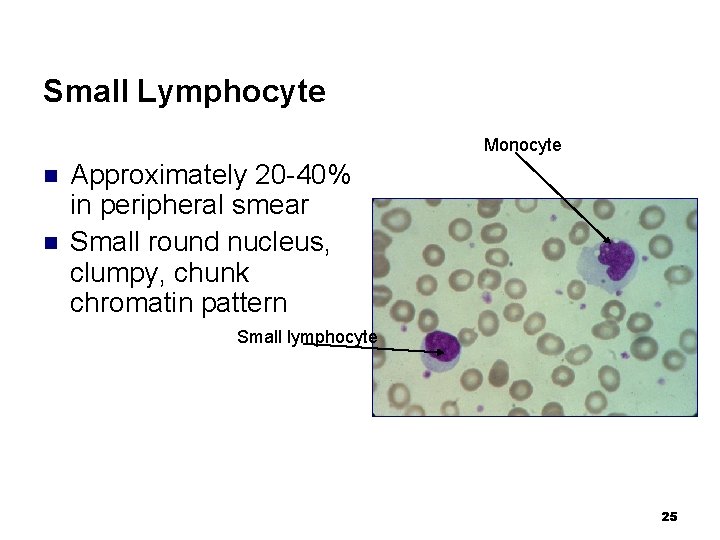
Small Lymphocyte Monocyte n n Approximately 20 -40% in peripheral smear Small round nucleus,
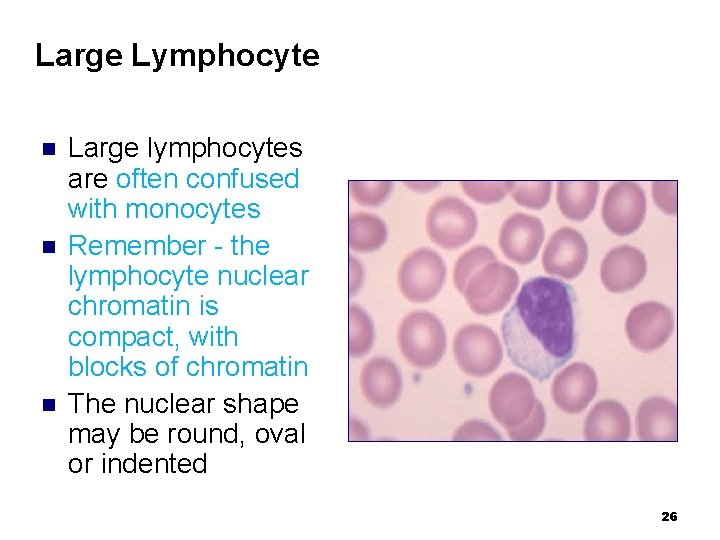
Large Lymphocyte n n n Large lymphocytes are often confused with monocytes Remember -
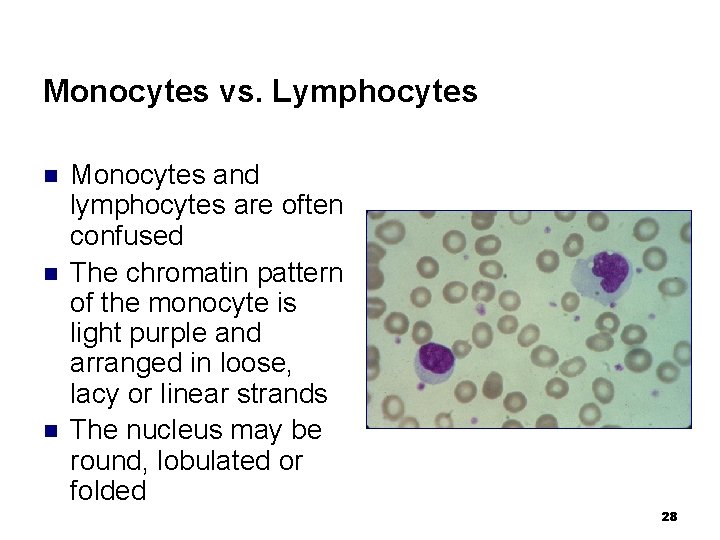
Monocytes vs. Lymphocytes n n n Monocytes and lymphocytes are often confused The chromatin
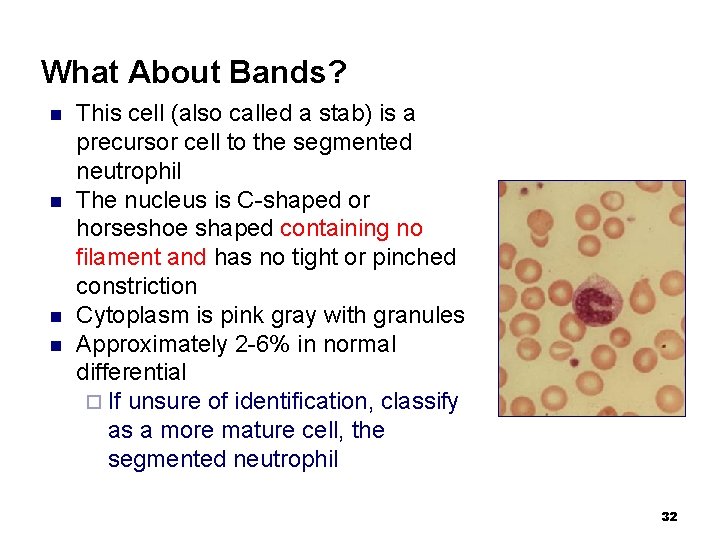
What About Bands? n n This cell (also called a stab) is a precursor
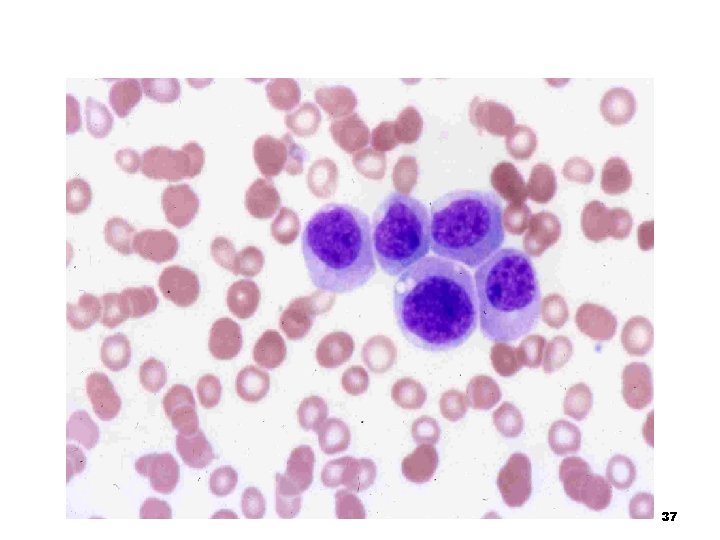
37
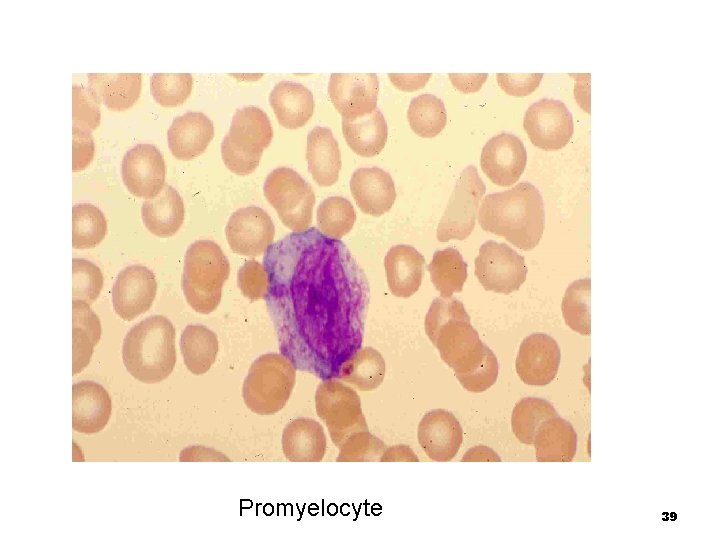
Promyelocyte 39
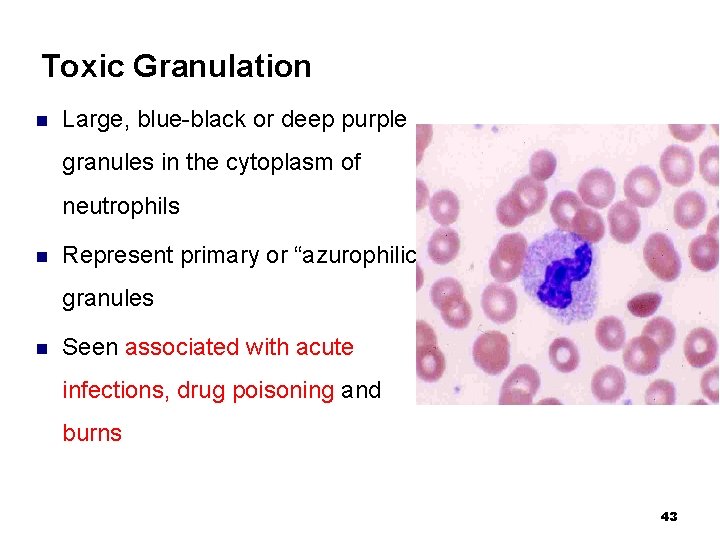
Toxic Granulation n Large, blue-black or deep purple granules in the cytoplasm of neutrophils
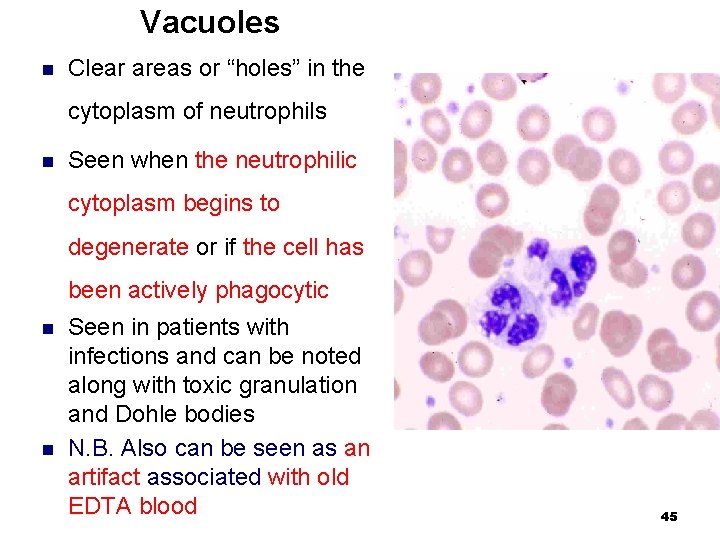
Vacuoles n Clear areas or “holes” in the cytoplasm of neutrophils n Seen when

CHAPTER 8 DIFFERENTIAL WHITE CELL COUNT Objectives After

CHAPTER 8 DIFFERENTIAL WHITE CELL COUNT

Objectives After completion of this chapter, the student will be able to: n Define differential leukocyte count (DLC) n Discuss three general features to be incorporated in the DLC n Perform a 100 cell differential count n Differentiate a relative cell count from an absolute cell count n Perform a WBC and platelet estimate on a stained peripheral blood smear 2

Objectives cont’d n Discuss the clinical implications of the differential leukocyte count n Identify mature and immature leukocytes n Identify morphological abnormalities of leukocytes n Identify reactive lymphocytes, including clinical situations associated with their presence n Identify possible sources of error and their remedies in DLC n Apply QC in DLC 3

8. 1 Introduction i. Differential white cell count: ¨ Is the enumeration of the relative proportions (percentages) of the various types of white cells as seen in stained blood films ¨ Is used to determine the relative numbers of each type of leukocyte. n A smear is examined and each time a leukocyte is seen, it is both tabulated and classified on a special counter n The counting and classifying continues until 100 cells have been observed 4

Diff count cont’d n The differential cell count also includes: ¨ an n evaluation of RBC morphology, ¨ platelet morphology and numbers, and ¨ general WBC morphology and estimation With a manual differential count, inaccuracy or deviation from the true count results both from: ¨ maldistribution ¨ misidentification of cells 5

Diff count cont’d n n n Maldistribution of cells: ¨ The different types of white cell are not distributed evenly over a slide ¨ The tail of the film contains: n more neutrophils n fewer lymphocytes, N. B. monocytes are fairly evenly distributed along the length of the film Large cells are preferentially distributed at the edges of the film Maldistribution of cells is aggravated: ¨ if a film is too thin or ¨ if a spreader with a rough edge has been used 6

Diff count cont’d ii. Clinical significance of Diff count n To evaluate the different leukocytes distribution in the circulation in normal and pathological states 7

Diff count cont’d iii. Principle of Differential white cell count n After taking blood sample, blood film is prepared, and after staining with Romanowsky stains, 100, 200, 300, etc. , cells will be counted; then the percent distribution of each cell is calculated iv. Type of specimen: EDTA anticoagulated venous or capillary blood v. Equipment and Reagents ¨ Microscope ¨ Diff counter ¨ Oil immersion ¨ Wright stain 8

8. 2. Methods of Counting n Various methods of tracking over a slide have been proposed to attempt to overcome errors due to maldistribution: ¨ The Longitudinal Strip Method ¨ The Battlement Method ¨ The Modified Battlement Method 9

A. The Longitudinal Strip Method n This is a method of tracking along the length of the film n The cells are counted using 100 x oil immersion objectives in a strip running the whole length of the film until 100 cells are counted. n If all the cells are counted in such a strip, the differential total will approximate closely to the true differential count 10

Longitudinal strip method cont’d Advantage and Disadvantages of the Method: Advatage: n It compensates for maldistribution between the body and the tail Disadvantage n It does not compensate for maldistribution between the centre and the edge ¨ i. e. , It does not allow for inclusion of neutrophils and monocytes 11

Longitudinal strip method cont’d Disadv cont’d n Difficulty in identifying contracted heavily stained cells in the thicker parts of the film (head part) ¨ However, this problem is minimized in a well made film and in practice brings little difference to results 12

B. The Battlement Method n n n Counting is performed by moving from side to side across the width of the slide in the counting area just behind the feather edge where the cells are separated from one another and are free from artifacts. Advantage ¨ It compensates for maldistribution between the centre and the edge Disadvantage ¨ It does not compensates for maldistribution between the body and the tail since the customary 100 -cell differential count will not cover a very large proportion of the length of the blood film 13

C. The Modified Battlement Method n n In modified battlement method, two fields are counted close to the edge parallel to the edge of the film, then four fields at right angles, then two fields parallel to the edge and so on. A modified battlement track is a compromise between the two methods. At least 100 cells should be counted. If there is white cell aggregation, the maldistribution of cells is so great that an accurate differential count is impossible. 14

Cont. . n Of the three methods: ¨ the longitudinal strip method appears to be the method of choice because it averages out almost all of the disadvantages of the two other methods n Multiple manual registers or electronic counters are used for the count. 15

Diff count cont’d Note: All elements of the blood film must be observed while performing the differential count. n If any abnormality is seen in the smear, it should be confirmed and reported The following points should be checked: ¨ Erythrocytes: size, shape, distribution, and degree of hemoglobinization ¨ presence of inclusion bodies ¨ presence of nucleated red cells, if so, the total leukocyte count must be corrected 16

Diff count cont’d n n n Platelets: ¨ Estimation (10 -20/HPF) ¨ Do they look normal? ¨ are there many giant or bizzare forms? Leukocytes: · Mature? Immature? Atypical? · Average number of lobes? Hypersegmented neutrophils? Hyposegmentation? · Hypergranulated ones? vacuolation? · Toxic granulation, other inclusions · Estimation · etc Hemoparasites: · malaria, borrelia, babesia, etc. 17

Diff count cont’d vi. Procedure n Using the 10 x dry objective, scan the smear for: ¨ Proper staining ¨ WBC distribution ¨ Presence of platelet clumps ¨ Presence of light blue fibrin strands which may indicate that the blood was not well mixed or partially clotted ¨ Any other unusual or irregular characteristics of cells n Using the 40 x dry objective, perform WBC estimate Platelet Clump 18

Performing a WBC Estimate Under 40 x High Dry n n n Look for estimate area which has 200 RBCs that are partially overlapping with many single red cells Determine a WBC estimate using the following conversion information (hpf=high power field): ¨ 2 -4 cells/hpf = 4. 0 – 7. 0 x 109/L Remember! ¨ 4 -6 cells/hpf = 7. 0 – 10. 0 x 109/L Estimates ¨ 6 -10 cells/hpf = 10. 0 – 13. 0 x 109/L are not 9 ¨ 10 -20 cells/hpf = 13. 0 – 18. 0 x 10 /L reported! Estimates: ¨ are reported as decreased, Increased, or adequate ¨ are used for QC purpose 19

Procedure cont’d n n n Locate a thin area of the smear in which the RBCs are evenly distributed, only slightly overlap, and the central pallor or “whites-of-their-eyes” is seen Place a drop of oil on the slide and switch to the oil immersion objective Change the objective to 100 x oil immersion Count 100 white cells including all cell lines from immature to mature Properly record and report results of differential cell counts. Note reference ranges and any abnormal results. 20

Evaluating Staining Properties n n n Locate a cell that can be positively identified, such as a polysegmented neutrophil. Note: the staining characteristics of the nucleus and cytoplasmic granules. Relate these features to any unidentified cells that may be present. 21

Evaluating Staining Properties cont’d n Myelocytes and metamyelocytes, if present, are recorded separately from neutrophils. n Band (stab) cells are generally counted as neutrophils but it may be useful to record them separately. ¨ An increase may point to an inflammatory process even in the absence of an absolute leucocytosis. 22

Evaluating Staining Properties cont’d n Remember that cells don’t always appear “picture” perfect. n The actual staining color of cells may vary from what is seen in textbooks or even in images. 23

Segmented Neutrophil Approximately 40 -75% in peripheral blood n 2 -5 lobes of nucleus n Joined by thin filament n Faint pink cytoplasm sprinkled with pink or purple neutrophilic granules n 24
Small Lymphocyte Monocyte n n Approximately 20 -40% in peripheral smear Small round nucleus, clumpy, chunk chromatin pattern Small lymphocyte 25
Large Lymphocyte n n n Large lymphocytes are often confused with monocytes Remember - the lymphocyte nuclear chromatin is compact, with blocks of chromatin The nuclear shape may be round, oval or indented 26

Monocyte n n n Approximately 5% in peripheral smear Large, convoluted, brainy looking nucleus with lacy looking chromatin Pale, gray blue, ground glass cytoplasm (numerous fine azurophilic granules) Monocyte nucleus can sometimes take many shapes from a band shape, to an oblong shape, to a convolutes brainy shape. What is important to remember is that the chromatin is lace, open weaved, and foamy looking. 27
Monocytes vs. Lymphocytes n n n Monocytes and lymphocytes are often confused The chromatin pattern of the monocyte is light purple and arranged in loose, lacy or linear strands The nucleus may be round, lobulated or folded 28

Basophil n n Approximately 0 -2% in peripheral blood Nucleus is bi-lobed and obscured by granules Cytoplasm is pale, washed out and contains intense large blue black granules Granules are scattered throughout the cell and it is hard to distinguish any distinct nuclear characteristics. 29

Eosinophil n n n Approximately 2 -7% in peripheral blood Bi-lobed or banded nucleus Large, red-orange and distinct granules To identify the eosinophil rely on the granules. The granules are very individualized looking. If the stain is right, then the cell will look orange red. If not, the cell will be washed-out looking. 30

What Does a Normal Adult Blood Smear Look Like? Segmented neutrophils ~60% Lymphocytes ~30% Monocytes ~5% Eosinophils, Basophils n ~3 -5% Remember, percentages are approximate and may differ with ethnic groups and in disease conditions What normal cell has not been discussed? 31
What About Bands? n n This cell (also called a stab) is a precursor cell to the segmented neutrophil The nucleus is C-shaped or horseshoe shaped containing no filament and has no tight or pinched constriction Cytoplasm is pink gray with granules Approximately 2 -6% in normal differential ¨ If unsure of identification, classify as a more mature cell, the segmented neutrophil 32

What About Immature Granulocytes? n n Metamyelocytes Myelocytes Promyelocytes Myeloblasts 33

Metamyelocyte n n n Also called a juvenile Rarely seen normally in the peripheral blood Nucleus characteristically indented or kidneyshaped The nuclear chromatin is clumped and condensed Specific granules appear the same as in the band 34

Metamyelocyte (bottom) and Band (top) 35

Myelocyte n Should never be seen in the peripheral blood n The nucleus is round or oval and often eccentrically located in the cell n The nuclear chromatin is beginning to clump; no nucleoli are visible n A moderate amount of patchy blue cytoplasm can be seen n The cell is characterized by the presence of light pink or tan (neutrophilic) specific granules 36
37

Promyelocyte n Should never be seen in the peripheral blood n Largest cell n The nucleus may be eccentric and slightly indented with nucleoli still visible n The nuclear chromatin is loose and open n The cell is characterized by the presence of few to many, prominent, dark red or purple cytoplasmic granules 38
Promyelocyte 39

Myeloblast n Should never be seen in the peripheral blood n Large cell (size may vary) n The nucleus is large and round, with one or more visible nucleoli n The nuclear chromatin is loose and open n The cytoplasm is scanty to moderate and deeply basophilic 40

Myeloblast 41

Abnormal Inclusions in Granulocytes (Neutrophils) n n n Toxic granulation Dohle bodies Vacuoles 42
Toxic Granulation n Large, blue-black or deep purple granules in the cytoplasm of neutrophils n Represent primary or “azurophilic” granules n Seen associated with acute infections, drug poisoning and burns 43

Dohle Bodies n Small, round or oval light-blue staining areas in the cytoplasm of neutrophils n Represent aggregates of rough endoplasmic reticulum n Seen in patients with infections, burns and after exposure to cytotoxic agents n May also be seen in conjunction with toxic granulation 44
Vacuoles n Clear areas or “holes” in the cytoplasm of neutrophils n Seen when the neutrophilic cytoplasm begins to degenerate or if the cell has been actively phagocytic n n Seen in patients with infections and can be noted along with toxic granulation and Dohle bodies N. B. Also can be seen as an artifact associated with old EDTA blood 45

Toxic Granules Dohle body Vacuoles 46

Reactive Changes in Lymphocytes n Response to a variety of viral and non-viral stimuli produce diverse nuclear and/or cytoplasmic changes in the lymphocytes ¨ Associated with viral infections, e. g. , Epstein-Barr virus (EBV), cytomegalovirus (CMV), human immunodeficiency virus (HIV) ¨ Also seen in response to drugs or non-viral organisms such as toxoplasmosis 47

Reactive Lymphocytes n Characteristics: ¨ Irregular shape of cytoplasm and/or nucleus ¨ Abundant dark blue cytoplasm, overall bigger cell ¨ Cytoplasmic ¨ Increased tags, sharp ridges; indented by red cells number of reddish granules or vacuoles in cytoplasm ¨ Fine nuclear chromatin pattern; may see nucleoli 48

Reactive Lymphocytes 49

8. 3. Reporting the Differential White Cell Count n The differential leukocyte count expressed as the percentage of each type of cell n It should be related to the total leukocyte count n The results reported in absolute numbers as the absolute value gives better clinical indication 50

Absolute vs. Relative Count Absolute count n Derived by multiplying the percentage of the identified cell times the white count ¨ ¨ If 40% lymphs are counted and the white cell count is 5. 0 x 109/L then the absolute lymphocyte count is 5. 0 x 109/L x. 40 or 2. 0 x 109/L This number is then compared to the healthy reference range Relative count n Strictly the percent counted in the WBC differential ¨ The relative number is then compared to the reference range for normal white cell differentials ¨ So, it is possible for an individual to have a relative increase, an absolute increase and a relative and absolute increase of a particular cell 51

Approximate Absolute and Relative Reference Ranges Values may vary according to geographic location Healthy Adult Cell Type Absolute Relative Segmented Neutrophil 2. 0 -7. 0 x 109/L 40. 0 -75. 0% Lymphocyte 1. 5 -4. 5 x 109/L 20 -45% Monocyte 0. 2 -0. 8 x 109/L 2 -10% Eosinophil 0. 04 -0. 4 x 109/L 0 -7% Basophil 0. 02 -0. 1 x 109/L 0 -2% 52

Quality control n n Well prepared well stained blood film which has 3 zones (Head, body, tail) WBC should contain blue nucleus along with a lighter staining cytoplasm RBC should have good quality of color ranging from buff pink to orange Platelet should be blue with granules and no nucleus 53

Sources of error n Use of unclean slide and improper smear preparation and staining technique n Counting cells in an area not suitable for counting n Misidentification of white cells n Interpersonal skill 54

8. 4. Interpretation of Differential White cell count n n For proper interpretation the relative count is of little use by itself For example, the fact that a sample may have 60% polymorphs is of little use A patient sample may have 60% neutrophil and a total leukocyte count of 8. 0 x 109/L giving 4. 8 x 109/L neutrophils, which is quite normal but if the patient has 60% neutrophils in a total leucocyte count of 3. 0 x 109/L, then the patient’s neutrophil count is 1. 8 x 109/L neutrophils. In this case the patient has granulocytopenia. 55

Interpretation cont’d 1. Neutrophil 1. 1 Neutrophilia/neutrophilic leucocytosis: ¨ an increase in the number of circulating neutrophils above normal (>2. 0 -7. 0 x 109/L) ¨ Overwhelming infections ¨ Metabolic disorders: uremia, diabetic acidosis ¨ Drugs and chemicals: lead, mercury, potassium chlorate ¨ Physical and emotional stress ¨ Hematological disorders: myelogenous leukemia ¨ Tissue destruction or necrosis: burns, surgical operations 56

Interpretation cont’d 1. 2. Neutropenia: n a reduction of the absolute neutrophil count below 2. 0 x 109/L ¨ Myeloid hypoplasia ¨ Drugs (chloramphenicol, phenylbutazone) ¨ Ionizing radiation 1. 3. Hypergranular neutrophils (neutrophils with toxic granules): these are ¨ neutrophils with coarse blue black or purple granules. ¨ indicative of severe infection or other toxic conditions. 57

Interpretation cont’d. . 1. 4 Vacuolation ¨ seen in progressive muscular dystrophy 1. 5. Hypersegmentation: ¨ neutrophils with more than six lobes to their nucleus (as many as ten or twelve may be seen) ¨ indicative of megaloblastic erythropoiesis (vitamin B 12 and/or folic acid deficiency), iron deficiency anemia and uremia. 1. 6. Agranular Neutrophils: ¨ neutrophils devoid of granules ¨ having a pale blue cytoplasm( features of leukemia) 58

Interpretation cont’d 2. Eosinophil 2. 1. Eosinophilia: ¨ an eosinophil count above 0. 5 x 109/L ¨ Occurs n during: Allergic diseases: bronchial asthma, seasonal rhinitis n Intestinal parasitic infections: e. g. trichinosis, taeniasis n Skin disorders n Chronic myelogenous leukemia 59

Interpretation cont’d 2. 2. Eosinopenia: ¨ an eosinophil count below 0. 04 x 109/L ¨ Occurs during: n Acute stress due to secretion of adrenal glucocorticoid and epinephrine n Acute inflammatory states 3. Basophilia: ¨ a basophil count above 0. 2 x 109/L ¨ Rare condition ¨ Occurs during: n Allergic reactions n Chronic myelogenous leukemia n Polycythemia vera 60

Interpretation cont’d 4. Monocyte 4. 1. Monocytosis: ¨ a monocyte count above 1. 0 x 109/l ¨ Occurs during n Recovery from acute infections n Tuberculosis n Monocytic leukemia 4. 2. Monocytopenia: ¨ a monocyte count below 0. 2 x 109/l ¨ Occurs during n Treatment with prednisone n Hairy cell leukemia 61

Interpretation cont’d 5. Lymphocytes 5. 1. Lymphocytosis: ¨ absolute lymphocyte count above 4. 0 x 109/L in adults and above 8. 0 x 109/L in children. ¨ Seen during n Infectious lymphocytosis associated with coxackie virus n Other viral infections: Epstein-Barr virus, cytomegalovirus n Acute and chronic lymphocytic leukemia n Toxoplasmosis 62

Interpretation cont’d 5. 2. Lymphocytopenia: ¨ a lymphocyte count below 1. 0 x 109/l in adults and below 3. 0 x 109/l in children ¨ Seen in n Immune deficiency disorders: HIV/AIDS n Drugs, radiation therapy Atypical lymphocytes: ¨ Large cell; abundant pale blue cytoplasm with peripheral basophilia, may have azurophilic granules ¨ They are primarily seen infectious mononucleosis which is an acute, selflimiting infectious disease of the reticuloendothelial tissues, especially the lymphatic tissues 63

Summary: Performing Differential Cell Counts n n n Use properly prepared and stained blood smears Establish a good counting area Properly identify white cells Provide an estimate of total white cells and platelets Record cellular morphology (RBC, WBC, and Plt) Properly record and report results noting reference ranges and abnormal results 64

Review Questions 1. 2. 3. 4. 5. Define differential leukocyte count. What is the importance reporting the differential leukocyte counts in absolute terms? What other elements of the blood film should be evaluated while doing the differential leukocyte count? Describe three tracking methods of diff counting with their advantage and disadvantage List at least five factors affecting the differential white cell count and their remedies 65
- Slides: 65